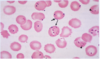

Travel Related Infection Flashcards
(56 cards)
Modern Tropical Medicine - lots of different diseases from a variety of _________
destinations
what are some unfamiliar features of imported diseases that people may experience?
- Presenting features
- Isolation requirements
- Diagnostic methods - Blood film for malaria
- Treatment/Management
- Unexpected complications - Bleeding, coma, shock, seizures
What increases vulnerability of travelers to infection?
- Temptation to take risks away from home - food, water, animals, sex
- Different epidemiology of some diseases - HIV, TB, polio, diphtheria
- Incomplete understanding of health hazards
- Stress of travel
- Refugees: deprivation, malnutrition, disease, injury
Some infections are common worldwide such as what?
- influenza
- community-acquired pneumonia
- meningococcal disease
- sexually transmitted diseases
Infections Controllable by Public Health measures include what? - Sanitation
Travelers’ diarrhoea
Typhoid
Hepatitis A or E
Giardiasis
Amoebiasis
Helminth infections
Viral gastroenteritis
Food poisoning
Shigella dysentery
Cholera
Cryptosporidiosis
Infections Controllable by Public Health measures include what? - Immunization
Poliomyelitis
Diphtheria
Infections Controllable by Public Health measures include what? - Education
HIV
STD’s
what are examples of Water-related infections? (drinnking and swimming)
- Schistosomiasis
- Leptospirosis
- Liver flukes
- Strongyloidiasis
- Hookworms
- Guinea worms
what are exmples of Arthropod-borne infections?
- Malaria (mosquitos)
- Dengue fever (mosquitos)
- Rickettsial infections (ticks: typhus)
- Leishmaniasis (sand flies: Kala-azar)
- Trypanosomiasis (tsetse fly: sleeping sickness)
- Filariasis (mosquitoes: elephantiasis)
- Onchocerciasis (black flies: River Blindness)
what are some Emerging Infectious Diseases?
- Zika: Latin America, Caribbean
- Ebola virus disease: West Africa
- MERS-CoV: Middle East
- Swine ‘flu (H1N1): worldwide
- Avian ‘flu (H5N1 and H7N9): China
- SARS: Far East, worldwide
- West Nile Virus: USA
- …etc.
what are some Important Tropical Diseases?
- Malaria
- Typhoid
- Dengue Fever
- Schistosomiasis
- Rickettsiosis
- Viral haemorrhagic fevers
- Zika fever
what is malaria?
Parasitic infection of the red blood cells of the human
what is the Epidemiology of malaria?
- Most important imported disease
- United Kingdom (HPA, 2015)
- 1400 cases/year
- 6 deaths/year
•Worldwide (WHO, 2012)
- 207 million cases/year
- 627,000 deaths/year
Disease of the tropics

what is the Malaria vector?
female Anopheles mosquito
what is the life cycle of malaria?
Injects sporozoites as it is taking a blood meal - they are premature forms of the parasite, migrate to liver and invade the liver cells and they replicate and then enter into the circulation, red blood cells
Female mosquito takes blood meal and the gametocytes fuse to form zygote and then the mosquito gets more sporozoites
Many drugs work in the different stages of this
7 days for this to happen

what are the 5 species of malaria and their severities?
Plasmodium falciparum - Potentially severe
“benign”:
- Plasmodium vivax
- Plasmodium ovale
- Plasmodium malariae
- Plasmodium knowlesi (like P malariae; Far East, 2004)
what are the symptoms of malaria?
Often vague and unspecific symptoms
Symptoms common to many infections
Often people think its influenza
- fever
- rigors
- aching bones
- abdo pain
- headache
- dysuria
- frequency
- sore throat
- cough
what are the signs of malaria?
- none
- splenomegaly
- hepatomegaly
- mild jaundice
what are some complications of malaria?
- Cerebral malaria (encephalopathy) - non- immune visitors, children in endemic areas hypoglycaemia, convulsions, hypoxia
- Blackwater fever - severe intravascular haemolysis, high parasitaemia, profound anaemia, haemoglobinuria, acute renal failure
- Pulmonary oedema
- Jaundice
- Severe anaemia
- Algid malaria - Gram-negative septicaemia
how is a diagnosis of malaria made?
- Thick & thin blood films - Giemsa, Field’s stain
- Quantitative buffy coat (QBC) - centrifugation, UV microscopy
- Rapid antigen tests - OptiMal, ParaSight-F
Diagnosis based on clinical suspension if a person has come back from a at risk area
(purple dots are malaria parasites)
Quantitative Buffy Coat (QBC) Test
Quantitative buffy coat (QBC) is a laboratory test to detect infection with malaria or other blood parasites

what is a blood film?
a thin layer of blood smeared on a glass microscope slide and then stained in such a way as to allow the various blood cells to be examined microscopically
Severity assessment:
Complicated malaria = one or more of…
- Impaired consciousness or seizures
- Hypoglycaemia
- Parasite count >=2%
- Haemoglobin <= 8mg/dL
- Spontaneous bleeding / DIC
- Haemoglobinuria
- Renal impairment or pH <7.3
- Pulmonary oedema or ARDS
- Shock (algid malaria) - ?Gram negative bacteraemia
what are the Treatment options for
uncomplicated P. falciparum malaria?
- Riamet ® (artemether-lumefantrine) 3 days
- Eurartesim ® (dihydroartemisinin-piperaquine) 3 days
- Malarone ® (atovaquone-proguanil) 3 days
- Quinine 7 days - S/E nausea, tinnitus, deafness (cinchonism), rash, hypoglycaemia - plus oral doxycycline (or clindamycin)



